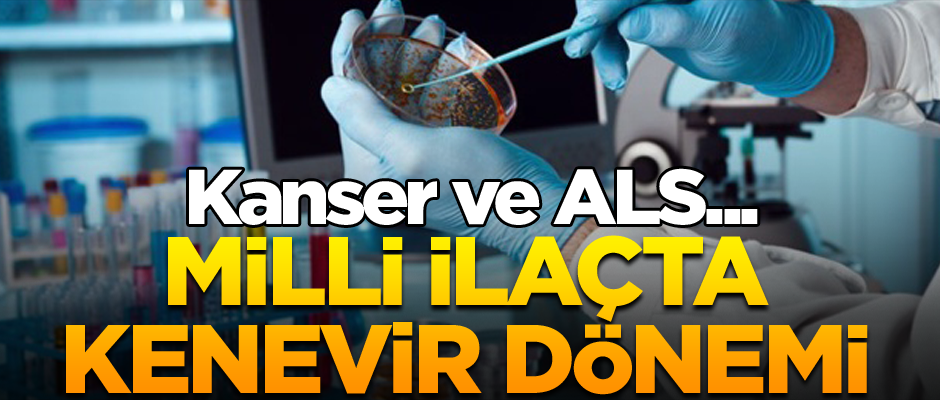
Milli ilaçta kenevir dönemi... Kanser ve ALS...

Cumhurbaşkanı Recep Tayyip Erdoğan’ın Türkiye’de yerli kenevir üretimine başlanacağı yönünde yaptığı açıklama, uyuşturucu madde imalatıyla özdeşleştirilen kenevirin farklı kullanım alanları ve faydalarını yeniden gündeme taşıdı.
Kenevir’in milli ilaç atılımında da büyük bir katkısı olabileceğini anlatan Avrasya Stratejik Araştırmalar Merkezi Kendir Enstitüsü Başkanı Dr. Erdem Ulaş, “Kenevir kanser ALS gibi hastalıklar başta olmak üzere 250 hastalığa fayda sağlayabilecek içeriğe sahip” dedi.
Piyasaya büyük katkı
Kenevirin ilaç piyasasına da büyük bir katkısı olacağını anlatan Ulaş, “1 tonluk (dişi) kenevirin saf yağı 15 bin avro civarında. Ayrıca antibakteriyel ipliğinden dolayı pantolondan plastik ürünlerinin tamamına dek birçok ürün kenevirden üretilebiliyor. Kenevir AIDS, kanser gibi birçok hastalığın tedavisinde kullanılırken, kemoterapi ve radyasyonun etkisini de azaltıyor” şeklinde konuştu.
Sağlık açısından da faydaları var
Doktor Erdem Ulaş, kenevir tohumlarının yüksek ısıya maruz kalmadan sıkılmasıyla kenevir yağı elde edildiğini söyledi. Bu yağın gıdaların hazırlanmasında ve pişirilmesinde kullanılabildiğini kaydeden Doktor Ulaş, “Sağlık için zararlı olan doymuş yağları az miktarda içerir ve besin değeri yüksektir. Kenevir yağı kötü kolesterolü düşürür, iyi kolesterolü yükseltir. Kalp sağlığını olumsuz yönde etkileyen rahatsızlıkları yok eder ve kan basıncını düşürür. Kenevir yağı, potasyum, kalsiyum, magnezyum, çinko, demir ve fosfor gibi birçok mineral maddeye sahiptir. Kenevir yağı hormonların dengelenmesi sağlar. Özellikle menopoz dönemindeki kadınlara fayda sağlayarak menopoz dönemi sağlığını destekler. Kenevir yağı omega-3 ve omega-6 kaynağı olduğu için kalp ve damar sağlığını korur. Omega-6 yağ asidi olan GLA açısından da zengindir” ifadelerini kullandı.
Kaynak: Yeni Şafak